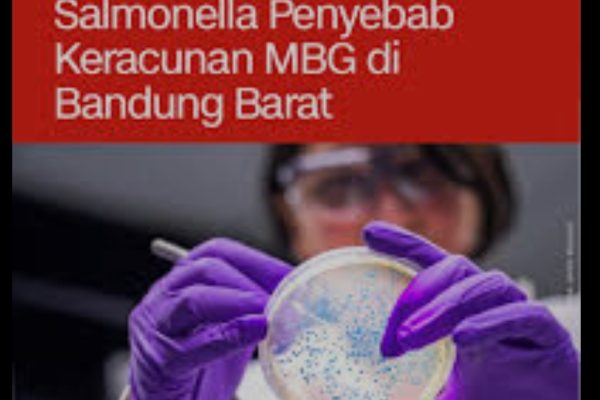

Kualitas Layanan dan Edukasi Gizi MBG 2026 Disorot
JAKARTA, Newsantara.co – Anggota Komisi IX DPR RI Netty Prasetiyani Aher mendorong peningkatan mutu layanan dan keamanan pangan dalam pelaksanaan Program Makan Bergizi Gratis (MBG) tahun 2026. Dorongan ini ia sampaikan menanggapi rencana Badan Gizi Nasional (BGN) yang akan memperluas cakupan program hingga menjangkau 55 juta anak Indonesia. Netty menilai, setelah fokus pada pembangunan infrastruktur…